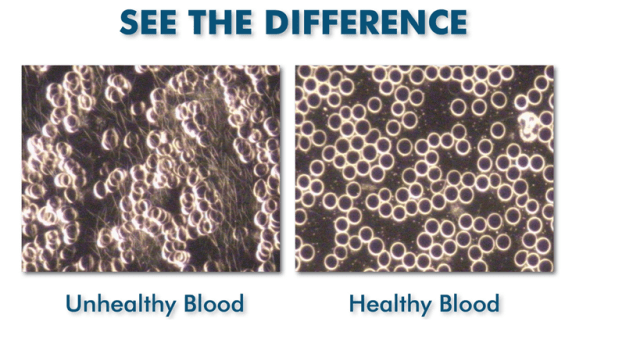

For such a hermit I have been really busy, but not so busy that it was too exhausting, the nice thing about a 4 day weekend is you can fit in recovery time.
The remainder of Easter weekend was lovely. At lunch time last Saturday I went to a friend’s for her birthday celebration and it was really hot outside. It was such a lovely afternoon spent talking to women who are authentic.
We laughed until my stomach was hurting, the proper belly laugh where we wept off our eyeliner and could not catch our breath. It was such a wonderful afternoon.
The next day my friend sent the name of Goddess / Lady ‘Baubo’ and said I must look into her. When I did I realised that she was obviously in our presence at lunch! Baubo was an ancient Greek Goddess also known as the Goddess of Obscenity. There are a variety of representations of Goddess Baubo, but in most of them she has no head, nipples for eyes and her vulva as her mouth.

In the myth of Persephone and Demeter, Baubo makes Demeter laugh by lifting her skirt and flashing her bits. In the Hymn to Demeter, she is called Iambe. In the Orphic fragments (specifically Orphic fragment 52) she is called Baubo.
This said, she drew aside her robes, and showed
A sight of shame; child Iacchus was there,
And laughing, plunged her hand below her breasts.
Then smiled the goddess, in her heart she smiled,
And drank the draught from out that glancing cup.
No matter how you interpret her, Baubo/Iambe is a tribute to the power and fertility of women’s laughter and women’s bodies. She represents the all encompassing Belly Laugh.
On Monday morning I went to see Loren my ‘health coach’ for my follow up appointment to check my progress as it has been a month since I went the first time. Norm drove me and I was really nervous in case things had not improved as I had been having a wee cheat here and there. Loren did a KARNAK scan and a finger prick, took my measurements and my weight. I have lost 3 kgs (6.5 pounds) since my last visit, but more importantly the BMI, Percentage Body Fat, extracellular water ratio and other measures we are working on are improving. I am not doing the change in eating specifically for weight loss, I am working towards body functionality improvements and lowering my inflammation levels, luckily these markers have improved. The water retention is gone from my feet and ankles. The results from the live blood analysis was so much better too, I had nice round blood cells and it looked far less full of random clutter. There was still a bit of the chaining but it was better.
She still sees a lot of cortisol in my body and gave me some supplements to deal with that so will see if they make a difference. I just feel proud that I managed to adhere to it most of the month and it made a positive effect on my body. Or was it just the leftover juju from Goddess Baubo and her belly laughs? We may never know.
Last Saturday evening we had plans to meet one of Norm’s colleagues for dinner. I did not know him and Norm confessed he knew him only vaguely. I was warned to stay sober at my girl’s lunch but I only achieved tipsy. We met up at Cheyne’s for dinner at 7pm.
The special is 4 dishes off of the menu for R420 per head. I had my usual cocktail the Passionate Buddha which contains Vodka, Fuji apple juice with roasted cardamon, ginger and fresh mint leaves shaken with passionfruit, star anise and mandarin puree topped with MCC. These beautiful little glasses of nectar are R120 as are many of their cocktails. But it is large and lasts a while.
We all chose 3 savoury dishes and 1 sweet one. I started with the Baby Shrimp Tempura, garlic Truffle Mayo and red pepper flakes.
Norm had the Hake Tempura, miso aioli, sauce unagi.
Next I had the Chili salt squid, Cajun furikake, green chili and dashi mayo.
For my third dish I had the Mumbai chili beef, cardamom, teriyaki, green chili and coconut.
For my dessert I chose the double thick peanut butter shake, miso butterscotch, toasted nuts and chocolate soil. Norm had the apple crumble with miso and cinnamon caramel, coconut and oat crumble with vanilla ice cream.
My meal was absolutely perfect. I give it 5 Kitten Stars ⭐⭐⭐⭐⭐
We snapped a pic on our way out but it was opposite a neon light which turned us into Oompah Loompas. I was so full I felt like one.
We got home late and I was absolutely finished! Luckily we had a whole day on Sunday to recover. I decided to cook a fillet of beef that I had in the fridge and put it in a marinade, made a big salad and waited on Norm to get home from walking Finn. We tried to put the gas ring on but it would not fire. It was not load-shedding so we assumed we had ran out of gas so Norm popped outside to change over the gas bottles. As he was busy, the sky opened and it poured sheets of pelting rain. When he hooked up the gas bottle he could feel the gas whooshing out of the pipe fitting and spotted a hole. So no cooking of anything on the stove top and I was so thrown by life I never thought of putting it in the oven. I had put the beef in the microwave to keep it from the cats and I forgot all about it until the next day.
The dogs were thrilled to get half a beef fillet for their Easter dinner. Never mind.
Lily did the cutest Easter pics of my granddaughter Amelia Ray. I have one of her from the front as my wallpaper on my phone and it makes me smile all day long.
Our family had an amazing announcement to make this week, my daughter Caitlin and her husband Wes are expecting a wee baby in October! They are calling it The Gherkin in the theme of Lily calling Millie ‘The Pickle’ until she was born. The babies will be about 15 months apart and will hopefully be besties.
The rest of the week was so busy with work but I updated my team lead that I had so much work still left to do and it eased up that pressure I was putting on myself to get it all done. Mom has been feeling a bit better but is still not up to her usual self. But at least we are not so worried now that she is on the mend. Now she just needs time to get her strength back.
One day this week I was feeling a bit low and Norm came home with the most beautiful flowers for me, just because. I am the luckiest woman in the world.
I have been keeping to my anti-inflammatory eating as best I can. I cooked a gammon and that served us for two nights. We had roasted beetroot both nights. The first night I made a salad of lettuce, fresh figs, goats cheese, and sliced cucumber.
The next night I made a baby spinach salad. I added a goats cheese with a black pepper coating, cucumber, avocado, fresh figs, pickled red onions, nuts and a few croutons.
Another night I roasted a pork fillet and butternut and steamed some cauliflower. I dusted the butternut with cinnamon to give it a bit more flavour and it was yummy. I missed my fresh salads though!
I am still not eating at night (after 7.30) and following the other changes. I do feel much better.
Today was our Women’s Soul Circle and it was held at Bodhi Breathwork here in Hout Bay. It is such a beautiful calming spot. I loved this lamp!!!
But the wind was howling like crazy outside the shelter of our little room. There is a huge storm warning on all weekend.
The topic of this month was ‘Ignite your Superpower’ and we went through a series of questions presented by Nikki the facilitator where we were supposed to think about ‘what we think we are good at doing’ or where we have special skills, or what other people come to us for, whether that be direction or laughs or whatever other people see in us as our special skill.
We did a guided meditation where we were on a boat and we floated up to an island and we hiked through the forest and came upon a village. We were to imagine ourselves in this village and what our role would be there. I imagined that I joined in with the village medicine woman as her apprentice so that I could understand more about the plants on the island and the particular superstitions or beliefs of the villagers.
This meditation brought up my past from when I was in Brunei with my boyfriend at the time. I had sailed on a catamaran and could see this so clearly when Nikki mentioned dragging my hand along the water. When we were walking through the forest I saw the forest in Brunei where I got lost and thought I was going to be eaten by wild animals. That is a story for another day though!
Next we broke out into 2 groups of 6 women and brainstormed what each of our Super Power names would be and what our super powers are. I feel my super power is my ability to manifest by communicating with my Ancestors and Creator. I can communicate with animals and love nature, so I was deemed Nature Goddess.
We were then given watercolour paints and asked to paint ourselves in our alternative personas. Nature Goddess has a murder of crows surrounding her. They provide her with information they can pick up from the Bird High Wire (you would not understand so do not try). She can communicate with all animals and plants and rescues animals in need.
It was such silly fun but it also made us recognise what other people see in us, even if we cannot always see it in ourselves.
Tonight Norm and I are off to a new Japanese restaurant in Hout Bay which I have been wanting to go to since it opened. I am very excited! Life is so good.
I hope you all have a wonderful weekend and week ahead.
Much love, Kisses from the Kitten x0x0x0x0x0x